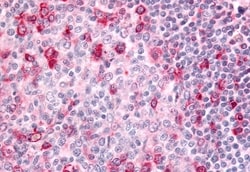
Invitrogen GPR183 Polyclonal Antibody 50 &mu;g; Unconjugated:Antibodies,

Promotional price valid on web orders only. Your contract pricing may differ. Interested in signing up for a dedicated account number?
Learn More
Learn More
Invitrogen™ GPR183 Polyclonal Antibody


Rabbit Polyclonal Antibody
Supplier: Invitrogen™ PA533673
Description
Percent identity with other species by BLAST analysis: Human, Gorilla, Monkey (100%) Marmoset, Mouse, Rat, Hamster, Elephant, Panda, Dog, Bat, Bovine, Horse, Rabbit, Pig (93%).
GPR183 was identified by the up-regulation of its expression upon Epstein-Barr virus infection of primary B lymphocytes. GPR183 is predicted to encode a G protein-coupled receptor that is most closely related to the thrombin receptor. Expression of this gene was detected in B-lymphocyte cell lines and lymphoid tissues but not in T-lymphocyte cell lines or peripheral blood T lymphocytes. The function of this gene is unknown.
Specifications
| GPR183 | |
| Polyclonal | |
| Unconjugated | |
| GPR183 | |
| EBI 2; Ebi2; EBV-induced gene 2; EBV-induced G-protein coupled receptor 2; EBV-induced G-protein coupled receptor 2 homolog; Epstein-Barr virus induced gene 2; Epstein-Barr virus induced gene 2 (lymphocyte-specific G protein-coupled receptor); epstein-Barr virus-induced G-protein coupled receptor 2; Epstein-Barr virus-induced G-protein coupled receptor 2 homolog; G protein-coupled receptor 183; GPR183; G-protein coupled receptor 183; RP11-461N23.2 | |
| Rabbit | |
| Antigen affinity chromatography | |
| RUO | |
| 1880 | |
| Store at 4°C short term. For long term storage, store at -20°C, avoiding freeze/thaw cycles. | |
| Liquid |
| Immunohistochemistry (Paraffin) | |
| 1 mg/mL | |
| PBS with 0.1% sodium azide | |
| P32249 | |
| GPR183 | |
| Synthetic 15 amino acid peptide from C-terminus of human GPR183 / EBI2. | |
| 50 μg | |
| Primary | |
| Human | |
| Antibody | |
| IgG |
Product Content Correction
Your input is important to us. Please complete this form to provide feedback related to the content on this product.
Product Title
Spot an opportunity for improvement?Share a Content Correction